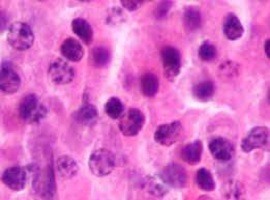
Anti-BCMA 抗体

Anti-BCMA 抗体
Anti-BCMA Antibody
询价
10μL
起订
广东 更新日期:2026-04-05
产品详情:
- 中文名称:
- Anti-BCMA 抗体
- 英文名称:
- Anti-BCMA Antibody
- 产品类别:
- 抗体
- 抗体类型:
- 一抗
公司简介
广州东锐科技有限公司成立于2003年初,经过公司全体员工十几年的持续辛勤耕耘,已发展成为华南地区最专业与专注的生物技术行业供
应商。
作为专业的服务型供应商,我们拥有众多从事生物技术及制药行业多年的资深人士;他们分别来自‘新药研究、工艺开发、质量控制、无菌生产’等技术岗位,可以为客户提供最专业而严谨的技术支持与服务。东锐科技每年定期为用户举办有针对性的技术交流会及行业研讨会,可以为用户提供学习新技术、理解新法规和行业交流的平台。
东锐科技是一家管理现代化的企业,采用金蝶公司ERP软件系统管理物流供应链,公司拥有650平方米的常用耗材仓库,可为特别的客户提供个性化及专享的库存物流服务。
● 想客户之所想,思客户之所忧,做客户之所需!
● 选择东锐就是选择品质、选择服务、选择安心!
| 成立日期 | (24年) |
| 注册资本 | 1000万人民币 |
| 员工人数 | 50-100人 |
| 年营业额 | ¥ 300万-500万 |
| 经营模式 | 贸易,试剂,服务 |
| 主营行业 | 生物化工,化学试剂 |
Anti-BCMA 抗体相关厂家报价 更多
-

- Anti-BCMA 抗体
- 苏州缔码生物科技有限公司
- 2026-04-05
- 询价
-

- 特异性 B 细胞成熟抗原 (BCMA) 肽/2293841-58-2/BCMA72-80
- 南京肽研生物科技有限公司 VIP
- 2026-04-08
- ¥450
-

- 人肿瘤坏死因子受体超家族成员17(TNFRSF17;BCMA)ELISA试剂盒
- 上海双赢生物科技有限公司 VIP
- 2026-04-08
- ¥1280
-

- 贝兰妥单抗,Belantamab,anti-BCMA antibody 抗体
- 武汉佰乐博生物技术有限公司 VIP
- 2026-04-08
- 询价